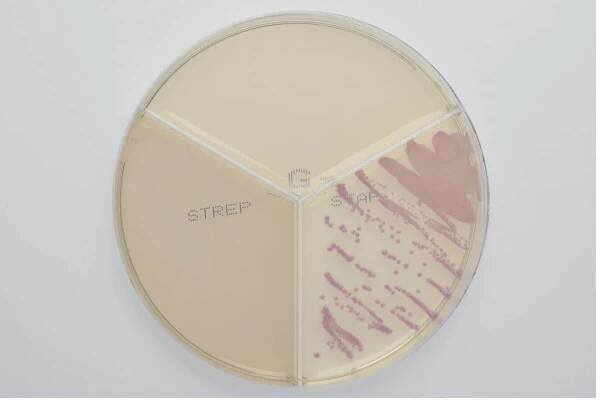

Nechtěli jste hledat staphylococcus aureus?
Staphylococcus aureus - Wikipedia
Staphylococcus aureus is a Gram-positive spherically shaped bacterium, a member of the Bacillota, and is a usual member of the microbiota of the body, frequently found in the upper respiratory tract and on the skin.
Staphylococcus aureus – Wikipedie
Staphylococcus aureus (také zlatý stafylokok) je grampozitivní bakterie patřící do rodu stafylokoků. Objevil ji v roce 1880 skotský chirurg Alexander Ogston v hnisu z otevřených poranění a o čtyři roky později ji německý bakteriolog F.
Neobsahuje yMusí obsahovat y
Methicillin-resistant Staphylococcus aureus (MRSA) Basics…
Protect yourself and your family from potentially serious MRSA infections.
Stafylokok – Wikipedie
Staphylococcus (z řec. staphyle, hrozen) je klinicky nejvýznamnější bakteriální rod čeledi Staphylococcaceae. Poprvé byly pozorovány z hnisu Louisem Pasteurem 1880.
Neobsahuje yMusí obsahovat y
Staphylococcus aureus - patogeneze, diagnostika a léčba…
Staphylococcus aureus (S.aureus, SA) je vysoce patogenní G+ bakterie, poměrně jasně vázaná na vemeno. Dle současného konceptu patří tedy do skupiny kontagiózních patogenů, jejichž přenos je vázaný primárně na dojírnu.
Neobsahuje yMusí obsahovat y
Nejvýznamnějším druhem rodu Staphylococcus je S
S. aureus se pomnožuje v potravinách ponechaných delší dobu při pokojové teplotě. Rizikové množství S. aureus v potravině, které je schopno vyprodukovat dostatečné množství SEs (alespoň 1 ng. g-1 potraviny), je 105 KTJ.g-1.
Neobsahuje yMusí obsahovat y
Staphylococcus aureus | NZIP
Staphylococcus aureus neboli „zlatý stafylokok“ je bakterie z rodu stafylokoků. Staphylococcus aureus je běžnou součástí lidské mikrobioty: často ...
Neobsahuje yMusí obsahovat y
Pediatr. praxi: Staphylococcus aureus jako původce…
Staphylococcus aureus (S. aureus) je významným patogenem způsobujícím komunitní i nozokomiální infekce u novorozenců, zejména na jednotkách intenzivní péče se podílí na vysoké incidenci invazivních infekcí.
Meticilin-rezistentní zlatý stafylokok – Wikipedie
Meticilin-rezistentní zlatý stafylokok (Meticilin-rezistentní Staphylococcus aureus, MRSA) je bakterie odpovědná za obtížně léčitelné infekce u lidí a zvířat.
Neobsahuje yMusí obsahovat y
odkazuje na služby nejen od Seznam.cz.
© 1996–2025 Seznam.cz, a.s.